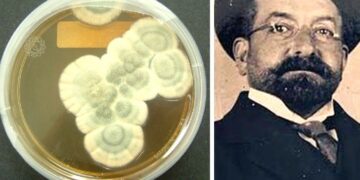
L’acqua ossigenata contro il Covid e Vincenzo Tiberio che anticipò Fleming

Popular News
-
Silvia Sardone molestia donna musulmana e la sua figlia minore per strada, la comunità islamica si mobilita
-
Musulmani italiani nel mirino del governo Israeliano: dossieraggio contro chi denuncia il genocidio
-
La cattiva coscienza dei fisici di Carlo Rovelli: i fisici, la bomba, ed il tempo che ci resta
-
Attentato islamofobo alla moschea di Cagliari: un attacco al cuore della convivenza pacifica
-
Remigrazione: il razzismo burocratico che vuole pagare gli stranieri per sparire